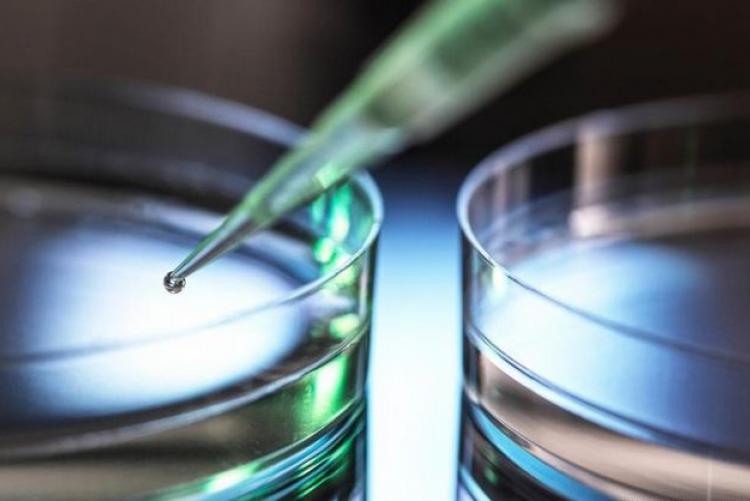

Abr
29
2022
0
By damian
Un grupo de investigadores descubrió el MCLA-158, candidato a fármaco, que podría prevenir la propagación de la enfermedad y también la metástasis.
Lee la nota completa en: